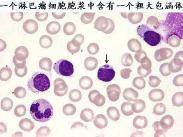
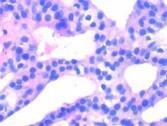

-
過敏性紫癜腎炎
628健康網(wǎng)為您分享有關(guān)過敏性紫癜腎炎的癥狀,過敏性紫癜腎炎的治療方法,過敏性紫癜腎炎的預(yù)防知識(shí),過敏性紫癜腎炎的癥狀...
-
白血病腎損害
628健康網(wǎng)為您分享有關(guān)白血病腎損害的癥狀,白血病腎損害的治療方法,白血病腎損害的預(yù)防知識(shí),白血病腎損害的癥狀圖片,白...
-
風(fēng)濕病性貧血
628健康網(wǎng)為您分享有關(guān)風(fēng)濕病性貧血的癥狀,風(fēng)濕病性貧血的治療方法,風(fēng)濕病性貧血的預(yù)防知識(shí),風(fēng)濕病性貧血的癥狀圖片,風(fēng)...
-
Castleman病
628健康網(wǎng)為您分享有關(guān)Castleman病的癥狀,Castleman病的治療方法,Castleman病的預(yù)防知識(shí),Castleman病的癥狀圖片,Castleman病吃什么藥,...
-
急性淋巴細(xì)胞性白血病
628健康網(wǎng)為您分享有關(guān)急性淋巴細(xì)胞性白血病的癥狀,急性淋巴細(xì)胞性白血病的治療方法,急性淋巴細(xì)胞性白血病的預(yù)防知識(shí)...
-
霍奇金淋巴瘤
628健康網(wǎng)為您分享有關(guān)霍奇金淋巴瘤的癥狀,霍奇金淋巴瘤的治療方法,霍奇金淋巴瘤的預(yù)防知識(shí),霍奇金淋巴瘤的癥狀圖片,霍...
-
慢性疾病的貧血
628健康網(wǎng)為您分享有關(guān)慢性疾病的貧血的癥狀,慢性疾病的貧血的治療方法,慢性疾病的貧血的預(yù)防知識(shí),慢性疾病的貧血的癥狀...
-
老年人再生障礙性貧血
628健康網(wǎng)為您分享有關(guān)老年人再生障礙性貧血的癥狀,老年人再生障礙性貧血的治療方法,老年人再生障礙性貧血的預(yù)防知識(shí)...
-
嗜堿性粒細(xì)胞增多癥
628健康網(wǎng)為您分享有關(guān)嗜堿性粒細(xì)胞增多癥的癥狀,嗜堿性粒細(xì)胞增多癥的治療方法,嗜堿性粒細(xì)胞增多癥的預(yù)防知識(shí),嗜堿性粒...
-
老年人真性紅細(xì)胞增多癥
628健康網(wǎng)為您分享有關(guān)老年人真性紅細(xì)胞增多癥的癥狀,老年人真性紅細(xì)胞增多癥的治療方法,老年人真性紅細(xì)胞增多癥的預(yù)防...
-
老年人急性淋巴細(xì)胞白血病
628健康網(wǎng)為您分享有關(guān)老年人急性淋巴細(xì)胞白血病的癥狀,老年人急性淋巴細(xì)胞白血病的治療方法,老年人急性淋巴細(xì)胞白血病...
-
小兒低鈉血癥
628健康網(wǎng)為您分享有關(guān)小兒低鈉血癥的癥狀,小兒低鈉血癥的治療方法,小兒低鈉血癥的預(yù)防知識(shí),小兒低鈉血癥的癥狀圖片,小...
-
先天性無(wú)轉(zhuǎn)鐵蛋白血癥
628健康網(wǎng)為您分享有關(guān)先天性無(wú)轉(zhuǎn)鐵蛋白血癥的癥狀,先天性無(wú)轉(zhuǎn)鐵蛋白血癥的治療方法,先天性無(wú)轉(zhuǎn)鐵蛋白血癥的預(yù)防知識(shí)...
-
老年人過敏性紫癜
628健康網(wǎng)為您分享有關(guān)老年人過敏性紫癜的癥狀,老年人過敏性紫癜的治療方法,老年人過敏性紫癜的預(yù)防知識(shí),老年人過敏性紫...
-
新生兒ABO溶血病
628健康網(wǎng)為您分享有關(guān)新生兒ABO溶血病的癥狀,新生兒ABO溶血病的治療方法,新生兒ABO溶血病的預(yù)防知識(shí),新生兒ABO溶血病的癥狀...
-
慢性腎性貧血
628健康網(wǎng)為您分享有關(guān)慢性腎性貧血的癥狀,慢性腎性貧血的治療方法,慢性腎性貧血的預(yù)防知識(shí),慢性腎性貧血的癥狀圖片,慢...
-
小兒白血病
628健康網(wǎng)為您分享有關(guān)小兒白血病的癥狀,小兒白血病的治療方法,小兒白血病的預(yù)防知識(shí),小兒白血病的癥狀圖片,小兒白血病...
-
小兒高黏稠綜合征
628健康網(wǎng)為您分享有關(guān)小兒高黏稠綜合征的癥狀,小兒高黏稠綜合征的治療方法,小兒高黏稠綜合征的預(yù)防知識(shí),小兒高黏稠綜合...
-
新生兒溶血病
628健康網(wǎng)為您分享有關(guān)新生兒溶血病的癥狀,新生兒溶血病的治療方法,新生兒溶血病的預(yù)防知識(shí),新生兒溶血病的癥狀圖片,新...
-
小兒紅白血病
628健康網(wǎng)為您分享有關(guān)小兒紅白血病的癥狀,小兒紅白血病的治療方法,小兒紅白血病的預(yù)防知識(shí),小兒紅白血病的癥狀圖片,小...
-
遺傳性蛋白S缺陷癥
628健康網(wǎng)為您分享有關(guān)遺傳性蛋白S缺陷癥的癥狀,遺傳性蛋白S缺陷癥的治療方法,遺傳性蛋白S缺陷癥的預(yù)防知識(shí),遺傳性蛋白...
-
黃色瘤
628健康網(wǎng)為您分享有關(guān)黃色瘤的癥狀,黃色瘤的治療方法,黃色瘤的預(yù)防知識(shí),黃色瘤的癥狀圖片,黃色瘤吃什么藥,黃色瘤怎么治...
-
真性紅細(xì)胞增多癥
628健康網(wǎng)為您分享有關(guān)真性紅細(xì)胞增多癥的癥狀,真性紅細(xì)胞增多癥的治療方法,真性紅細(xì)胞增多癥的預(yù)防知識(shí),真性紅細(xì)胞增多...
-
慢性腰背痛
628健康網(wǎng)為您分享有關(guān)慢性腰背痛的癥狀,慢性腰背痛的治療方法,慢性腰背痛的預(yù)防知識(shí),慢性腰背痛的癥狀圖片,慢性腰背痛...
-
小兒過敏性紫瘢
628健康網(wǎng)為您分享有關(guān)小兒過敏性紫瘢的癥狀,小兒過敏性紫瘢的治療方法,小兒過敏性紫瘢的預(yù)防知識(shí),小兒過敏性紫瘢的癥狀...
-
肌病腎病性代謝綜合征
628健康網(wǎng)為您分享有關(guān)肌病腎病性代謝綜合征的癥狀,肌病腎病性代謝綜合征的治療方法,肌病腎病性代謝綜合征的預(yù)防知識(shí)...
-
小兒原發(fā)性腹膜炎
628健康網(wǎng)為您分享有關(guān)小兒原發(fā)性腹膜炎的癥狀,小兒原發(fā)性腹膜炎的治療方法,小兒原發(fā)性腹膜炎的預(yù)防知識(shí),小兒原發(fā)性腹膜...
-
老年人多器官功能衰竭
628健康網(wǎng)為您分享有關(guān)老年人多器官功能衰竭的癥狀,老年人多器官功能衰竭的治療方法,老年人多器官功能衰竭的預(yù)防知識(shí)...
-
小兒腎性貧血
628健康網(wǎng)為您分享有關(guān)小兒腎性貧血的癥狀,小兒腎性貧血的治療方法,小兒腎性貧血的預(yù)防知識(shí),小兒腎性貧血的癥狀圖片,小...
-
反流性腎病
628健康網(wǎng)為您分享有關(guān)反流性腎病的癥狀,反流性腎病的治療方法,反流性腎病的預(yù)防知識(shí),反流性腎病的癥狀圖片,反流性腎病...
-
異常γ-球蛋白血癥
628健康網(wǎng)為您分享有關(guān)異常γ-球蛋白血癥的癥狀,異常γ-球蛋白血癥的治療方法,異常γ-球蛋白血癥的預(yù)防知識(shí),異常γ-球蛋白血...
-
老年人低鈉血癥
628健康網(wǎng)為您分享有關(guān)老年人低鈉血癥的癥狀,老年人低鈉血癥的治療方法,老年人低鈉血癥的預(yù)防知識(shí),老年人低鈉血癥的癥狀...
-
藥物過敏
628健康網(wǎng)為您分享有關(guān)藥物過敏的癥狀,藥物過敏的治療方法,藥物過敏的預(yù)防知識(shí),藥物過敏的癥狀圖片,藥物過敏吃什么藥,藥...
-
老年人脫水
628健康網(wǎng)為您分享有關(guān)老年人脫水的癥狀,老年人脫水的治療方法,老年人脫水的預(yù)防知識(shí),老年人脫水的癥狀圖片,老年人脫水...
-
老年人泌尿系統(tǒng)感染
628健康網(wǎng)為您分享有關(guān)老年人泌尿系統(tǒng)感染的癥狀,老年人泌尿系統(tǒng)感染的治療方法,老年人泌尿系統(tǒng)感染的預(yù)防知識(shí),老年人泌...
-
小兒乙型肝炎病毒相關(guān)腎炎
628健康網(wǎng)為您分享有關(guān)小兒乙型肝炎病毒相關(guān)腎炎的癥狀,小兒乙型肝炎病毒相關(guān)腎炎的治療方法,小兒乙型肝炎病毒相關(guān)腎炎...
-
胸內(nèi)腎
628健康網(wǎng)為您分享有關(guān)胸內(nèi)腎的癥狀,胸內(nèi)腎的治療方法,胸內(nèi)腎的預(yù)防知識(shí),胸內(nèi)腎的癥狀圖片,胸內(nèi)腎吃什么藥,胸內(nèi)腎怎么治...
-
原發(fā)性單克隆球蛋白病腎損害
628健康網(wǎng)為您分享有關(guān)原發(fā)性單克隆球蛋白病腎損害的癥狀,原發(fā)性單克隆球蛋白病腎損害的治療方法,原發(fā)性單克隆球蛋白病...
-
衣原體尿路感染
628健康網(wǎng)為您分享有關(guān)衣原體尿路感染的癥狀,衣原體尿路感染的治療方法,衣原體尿路感染的預(yù)防知識(shí),衣原體尿路感染的癥狀...
-
原發(fā)性小血管炎性腎損害
628健康網(wǎng)為您分享有關(guān)原發(fā)性小血管炎性腎損害的癥狀,原發(fā)性小血管炎性腎損害的治療方法,原發(fā)性小血管炎性腎損害的預(yù)防...
-
陰痹
628健康網(wǎng)為您分享有關(guān)陰痹的癥狀,陰痹的治療方法,陰痹的預(yù)防知識(shí),陰痹的癥狀圖片,陰痹吃什么藥,陰痹怎么治療,陰痹患者食...
-
重鏈病
628健康網(wǎng)為您分享有關(guān)重鏈病的癥狀,重鏈病的治療方法,重鏈病的預(yù)防知識(shí),重鏈病的癥狀圖片,重鏈病吃什么藥,重鏈病怎么治...
-
血尿
628健康網(wǎng)為您分享有關(guān)血尿的癥狀,血尿的治療方法,血尿的預(yù)防知識(shí),血尿的癥狀圖片,血尿吃什么藥,血尿怎么治療,血尿患者食...
-
脂肪營(yíng)養(yǎng)不良
628健康網(wǎng)為您分享有關(guān)脂肪營(yíng)養(yǎng)不良的癥狀,脂肪營(yíng)養(yǎng)不良的治療方法,脂肪營(yíng)養(yǎng)不良的預(yù)防知識(shí),脂肪營(yíng)養(yǎng)不良的癥狀圖片,脂...
-
痛風(fēng)性腎病
628健康網(wǎng)為您分享有關(guān)痛風(fēng)性腎病的癥狀,痛風(fēng)性腎病的治療方法,痛風(fēng)性腎病的預(yù)防知識(shí),痛風(fēng)性腎病的癥狀圖片,痛風(fēng)性腎病...
-
慢性腎衰竭
628健康網(wǎng)為您分享有關(guān)慢性腎衰竭的癥狀,慢性腎衰竭的治療方法,慢性腎衰竭的預(yù)防知識(shí),慢性腎衰竭的癥狀圖片,慢性腎衰竭...
-
小兒尿路感染
628健康網(wǎng)為您分享有關(guān)小兒尿路感染的癥狀,小兒尿路感染的治療方法,小兒尿路感染的預(yù)防知識(shí),小兒尿路感染的癥狀圖片,小...
-
中毒性腎病
628健康網(wǎng)為您分享有關(guān)中毒性腎病的癥狀,中毒性腎病的治療方法,中毒性腎病的預(yù)防知識(shí),中毒性腎病的癥狀圖片,中毒性腎病...
-
重金屬中毒性腎病
628健康網(wǎng)為您分享有關(guān)重金屬中毒性腎病的癥狀,重金屬中毒性腎病的治療方法,重金屬中毒性腎病的預(yù)防知識(shí),重金屬中毒性腎...
-
小兒IgA腎病
628健康網(wǎng)為您分享有關(guān)小兒IgA腎病的癥狀,小兒IgA腎病的治療方法,小兒IgA腎病的預(yù)防知識(shí),小兒IgA腎病的癥狀圖片,小兒IgA腎病...
熱點(diǎn)疾病
- 1 應(yīng)激性潰瘍 5929
- 2 盤狀紅斑狼瘡 5928
- 3 肉芽腫 5534
- 4 甲狀腺炎 4675
- 5 海綿腎 4408
- 6 心理障礙 4180
- 7 重癥急性呼吸綜合征 3808
- 8 木村病 3760
- 9 布加氏綜合征 1204
- 10 生長(zhǎng)障礙 1113